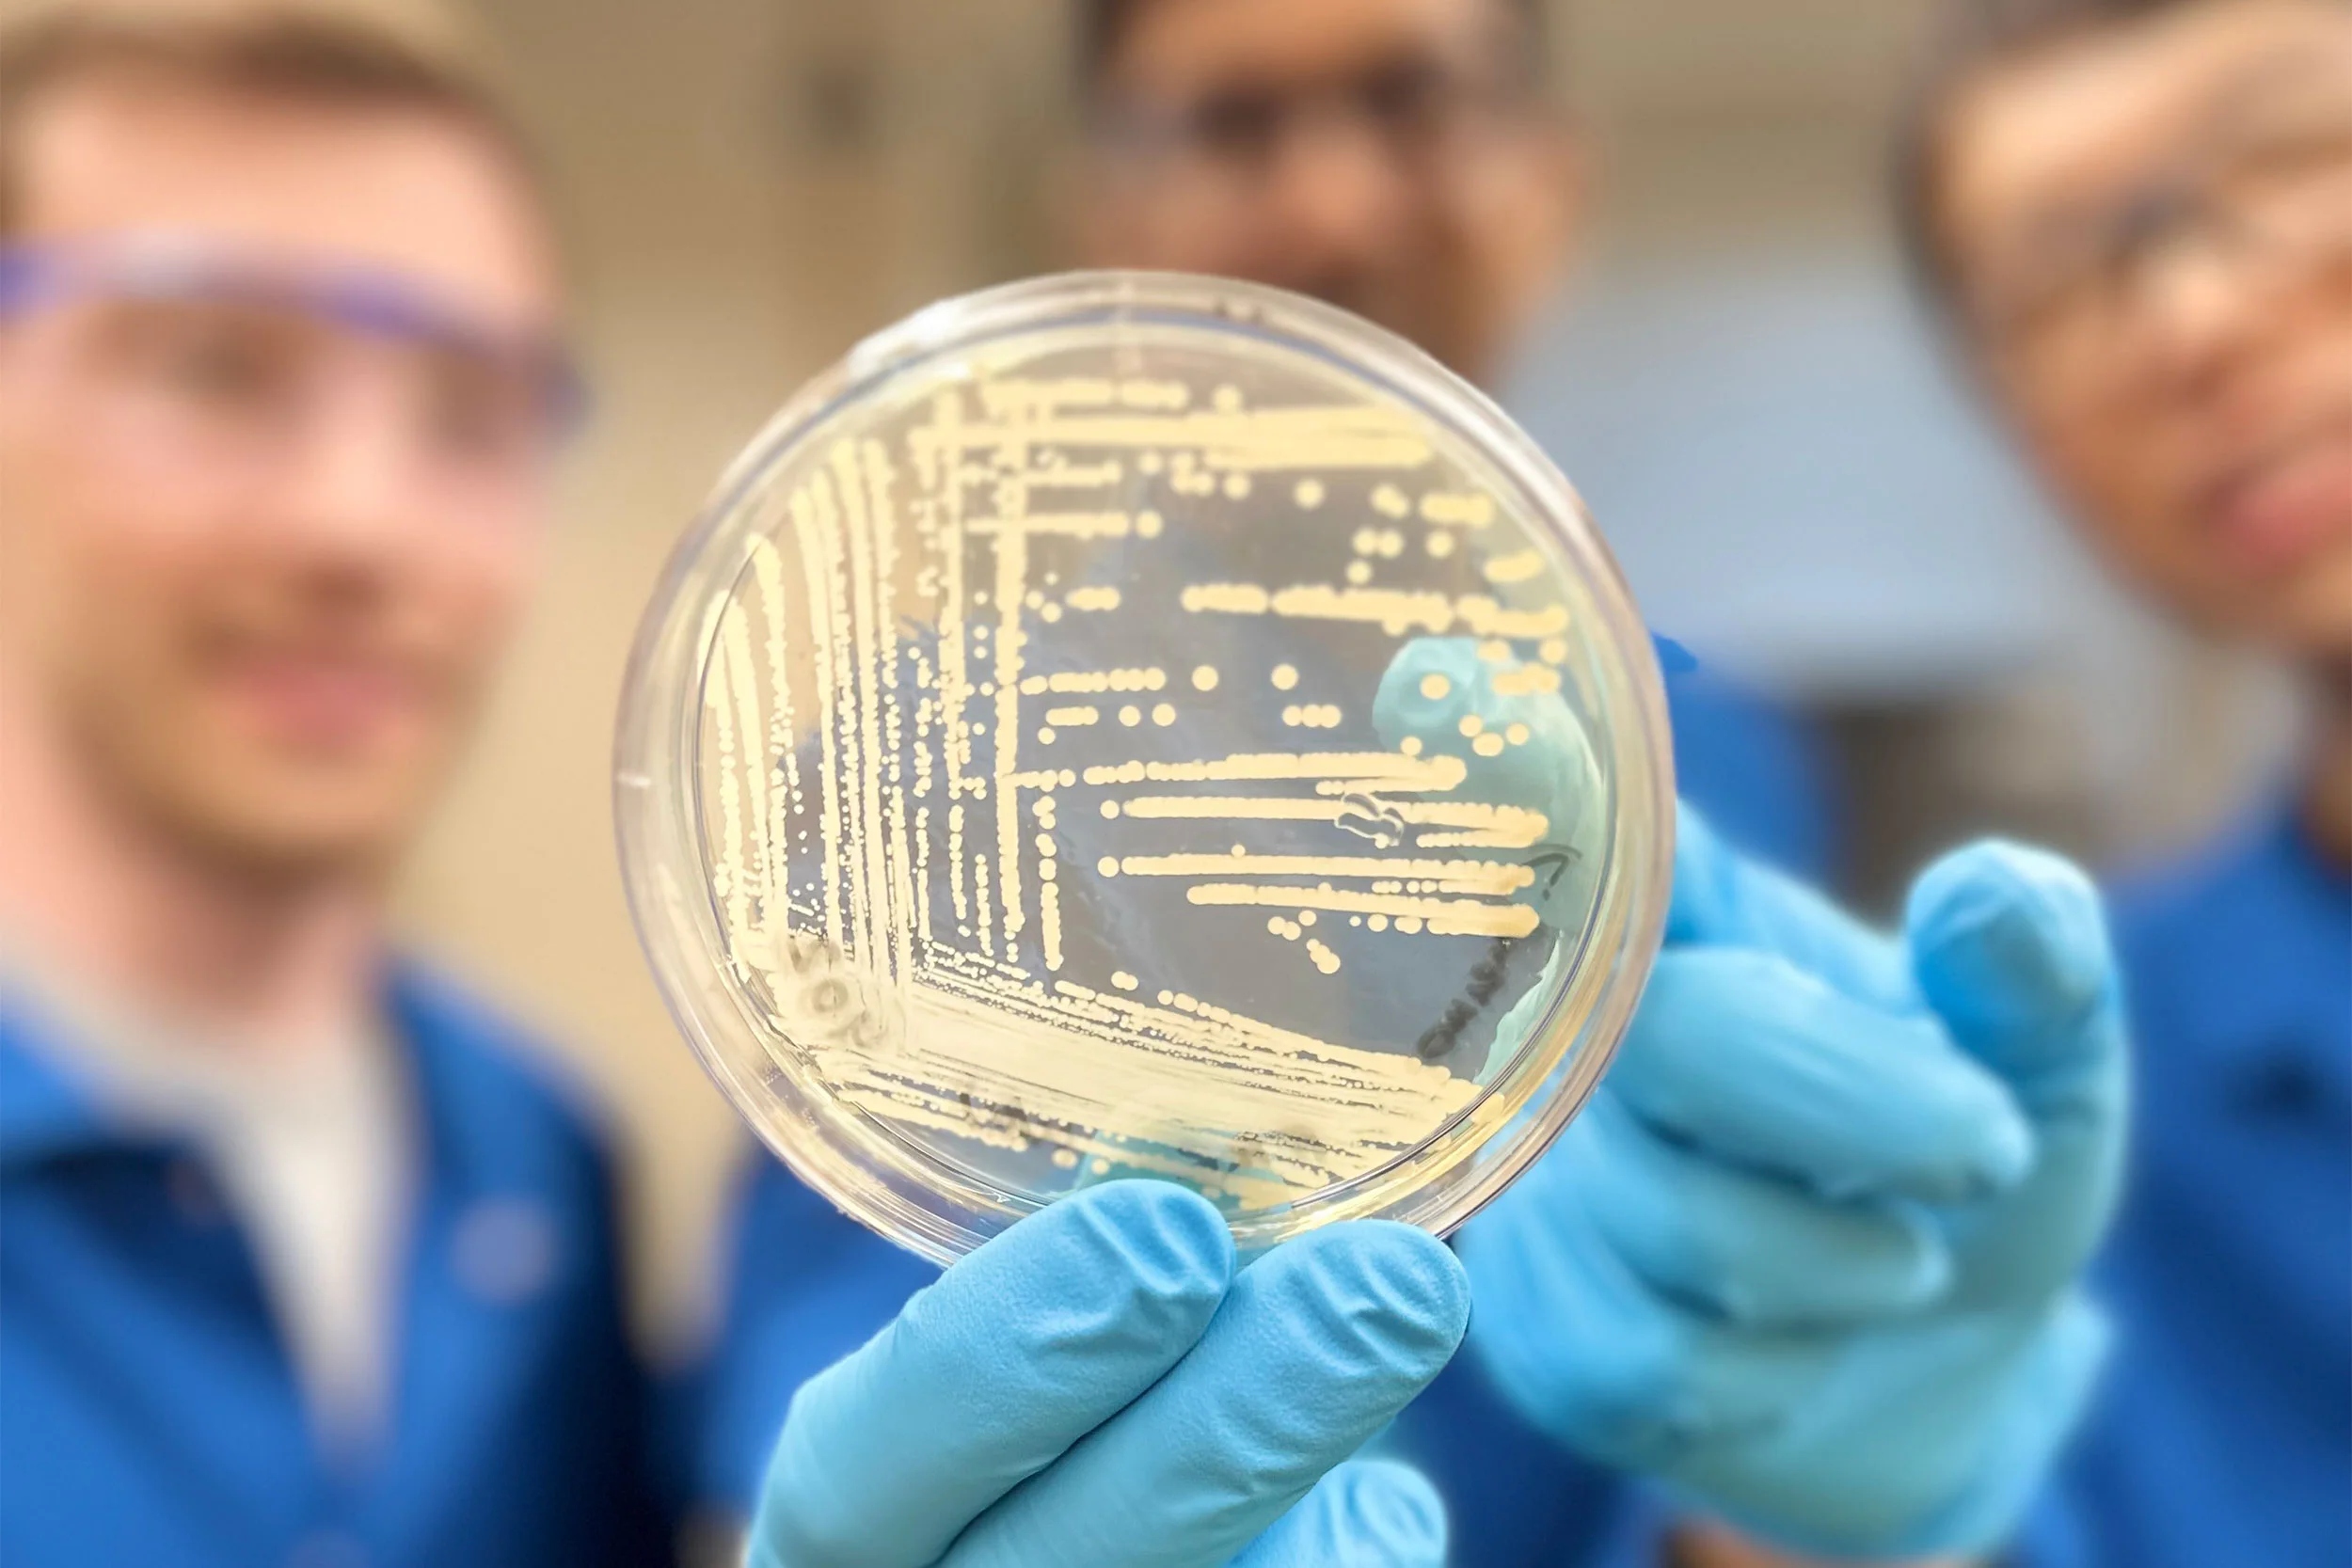

Ερευνητές από τα πανεπιστήμια Χάρβαρντ και Ιλινόι δημιούργησαν ένα νέο μόριο που εξουδετέρωσε αποτελεσματικά πολλούς τύπους βακτηρίων όταν δοκιμάστηκε σε ζώα. Πρόκειται για το cresomycin το οποίο έδειξε ότι μπορεί να σκοτώσει πολλά στελέχη βακτηρίων ανθεκτικών στα αντιβιοτικά, όπως ο Staphylococcus aureus και η Pseudomonas aeruginosa. Το cresomycin δεν έχει ακόμη αναπτυχθεί ως φάρμακο, ούτε είναι έτοιμο να δοκιμαστεί σε κλινικές δοκιμές σε ανθρώπους. Αποτελεί όμως ένα αρκετά ελπιδοφόρο βήμα προς την ανάπτυξη νέων θεραπειών.
«Τα αντιβιοτικά αποτελούν το θεμέλιο πάνω στο οποίο στηρίζεται η σύγχρονη ιατρική. Χωρίς αντιβιοτικά, πολλές ιατρικές διαδικασίες αιχμής, όπως χειρουργικές επεμβάσεις, θεραπείες καρκίνου και μεταμοσχεύσεις οργάνων, είναι αδύνατο να πραγματοποιηθούν», δήλωσε ο συν-συγγραφέας της μελέτης Κέλβιν Γου.
Το cresomycin ανήκει σε μια κατηγορία αντιβιοτικών γνωστών ως ενισχυμένες λινκοσαμίδες. Λειτουργεί στοχεύοντας το ριβόσωμα ενός βακτηρίου, το μικροσκοπικό εργοστάσιο πρωτεϊνών που βρίσκεται σε κάθε ζωντανό κύτταρο. Ακριβώς όπως αυτές οι μηχανές παίρνουν πλαστικά μόρια και τα χρησιμοποιούν για να κατασκευάσουν αντικείμενα οποιουδήποτε σχήματος, τα ριβοσώματα παίρνουν γενετικές πληροφορίες από το RNA και τις χρησιμοποιούν για να δημιουργήσουν πρωτεΐνες.
«Τα ριβοσώματα είναι κάτι σαν μοριακός τρισδιάστατος εκτυπωτής», δήλωσε ο Γιούρι Πολικάνοφ, δομικός βιολόγος στο Πανεπιστήμιο του Ιλινόι στο Σικάγο και συν-συγγραφέας της μελέτης.
Δεδομένου ότι οι πρωτεΐνες είναι απαραίτητες για όλες σχεδόν τις κυτταρικές δραστηριότητες, τα ριβοσώματα είναι ζωτικής σημασίας για τα βακτήρια. Αυτός είναι ο λόγος για τον οποίο πολλά αντιβιοτικά έχουν σχεδιαστεί για να τα στοχεύουν. Ωστόσο, τα βακτήρια εξελίσσονται συνεχώς και υιοθετούν νέους μηχανισμούς για να επιβιώσουν. Σε ορισμένες περιπτώσεις, το κάνουν αυτό εισάγοντας μια μεθυλομάδα, στο ριβόσωμά τους. Όταν ένα αντιβιοτικό προσπαθεί να συνδεθεί με το ριβόσωμα, η μεθυλομάδα το απωθεί.
Η μεθυλομάδα λειτουργεί σαν μια μικροσκοπική ακίδα που έχει τοποθετηθεί στη θέση που ήλπιζε να καταλάβει το αντιβιοτικό, εξήγησε ο Πολικάνοφ. Αλλά σε αντίθεση με τα προηγούμενα αντιβιοτικά, το νέο μόριο συνδέεται τόσο στενά με το ριβόσωμα που ουσιαστικά αναιρεί την επίδραση της μεθυλομάδας.
Στη νέα μελέτη, η οποία δημοσιεύθηκε στο επιστημονικό περιοδικό «Science», οι επιστήμονες κατασκεύασαν το συνθετικό μόριο σε ένα άκαμπτο σχήμα που μοιάζει πολύ με τον στόχο πρόσδεσής του και διαπίστωσαν ότι είναι αξιοσημείωτα αποτελεσματική έναντι πολλαπλών μορφών βακτηρίων. Για παράδειγμα, τα πειράματα έδειξαν ότι το νέο μόριο μπορεί να αναστείλει την ανάπτυξη δύο κύριων τύπων βακτηρίων, συμπεριλαμβανομένων των πολυανθεκτικών στελεχών Staphylococcus aureus, Escherichia coli και Pseudomonas aeruginosa τόσο σε εργαστηριακές δοκιμές καλλιέργειας όσο και σε ένα μοντέλο ποντικιού.
«Δεν υποδεικνύουμε ότι το μόριο είναι πλήρως βελτιστοποιημένο για την αναστολή του βακτηριακού ριβοσώματος», έγραψαν οι επιστήμονες, προσθέτοντας ωστόσο ότι τα «ευρήματα προμηνύουν ευνοϊκά για τη μελλοντική ανακάλυψη αντιβακτηριακών παραγόντων ευρέως αποτελεσματικών κατά της μικροβιακής αντοχής».
ΠΗΓΗ: Independent
www.ertnews.gr






